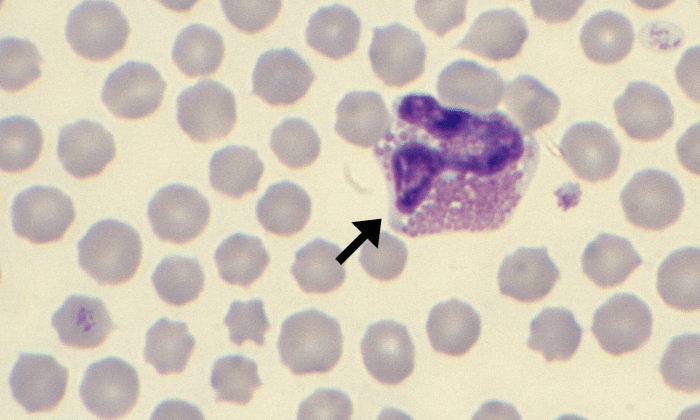
Eosinophils 7 (Bovine 1) ARROWS
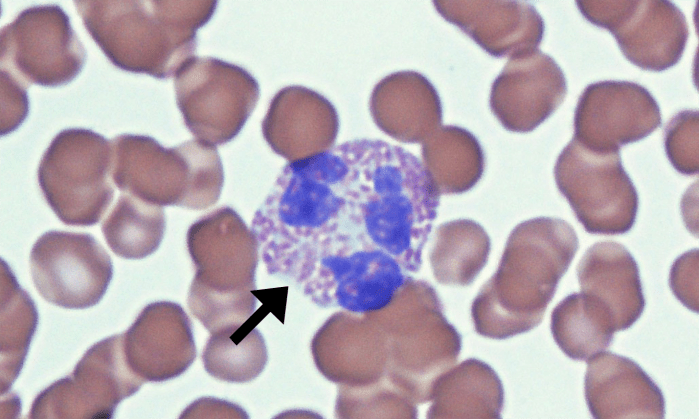
Eospinophils 11 (Feline 1) ARROWS
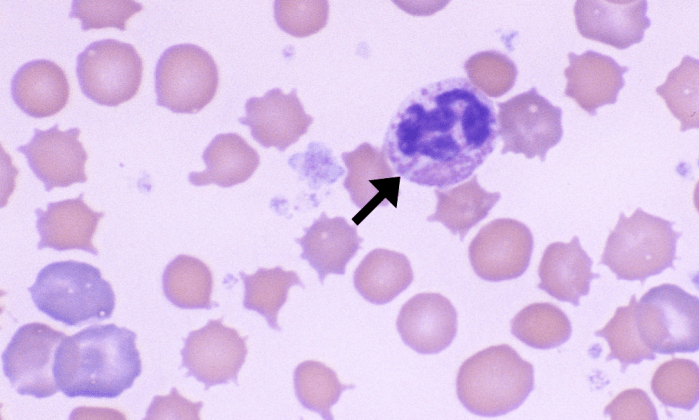
Eosinophils 10 (Rabbit 1) ARROWS

Eosinophils
Morphology: granulocyte with a segmented (often bi-lobed) nucleus and numerous pink-to-orange (eosinophilic) cytoplasmic granules. Considerable species variation in number, size, and shape of eosinophil granules. Considerable variation within and between dog breeds regarding number, size, and shape of eosinophil granules.
Look alike: other granulocytes (neutrophils, basophils)
Clinical relevance: eosinophils may be seen in small numbers in the blood of healthy animals. Eosinophilia (↑ eosinophils in peripheral blood) is usually associated with allergies/hypersensitivities or parasitic infections and is often accompanied by basophilia.